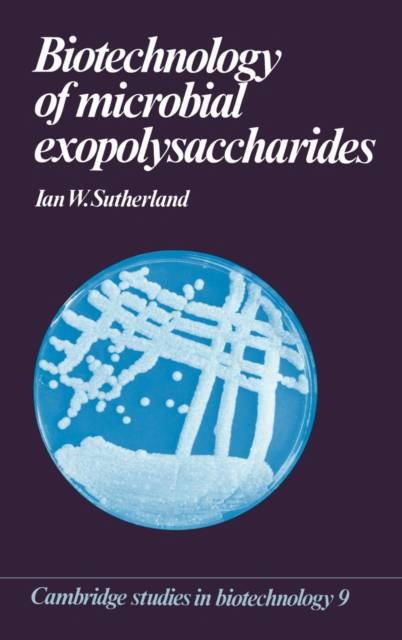

En raison d'une grève chez bpost, des retards de livraison peuvent survenir. Besoin de quelque chose en urgence ? Optez pour un retrait en magasin ou rendez-vous dans une Librairie Club à proximité.
- Retrait en 2 heures
- Assortiment impressionnant
- Paiement sécurisé
- Toujours un magasin près de chez vous
En raison d'une grève chez bpost, des retards de livraison peuvent survenir. Besoin de quelque chose en urgence ? Optez pour un retrait en magasin ou rendez-vous dans une Librairie Club à proximité.
- Retrait en 2 heures
- Assortiment impressionnant
- Paiement sécurisé
- Toujours un magasin près de chez vous
Description
This volume provides a thorough account of the structure and synthesis of microbial exopolysaccharides and of their widespread application across a broad range of industries, including food, oil and medicine. The successful exploitation of these polysaccharides requires a sound scientific understanding of their chemical and physical properties and also their biochemistry and biosynthesis.
Spécifications
Parties prenantes
- Auteur(s) :
- Editeur:
Contenu
- Nombre de pages :
- 172
- Langue:
- Anglais
- Collection :
- Tome:
- n° 9
Caractéristiques
- EAN:
- 9780521363501
- Date de parution :
- 18-10-90
- Format:
- Livre relié
- Format numérique:
- Genaaid
- Dimensions :
- 163 mm x 235 mm
- Poids :
- 449 g

Seulement chez Librairie Club
Les avis
Nous publions uniquement les avis qui respectent les conditions requises. Consultez nos conditions pour les avis.